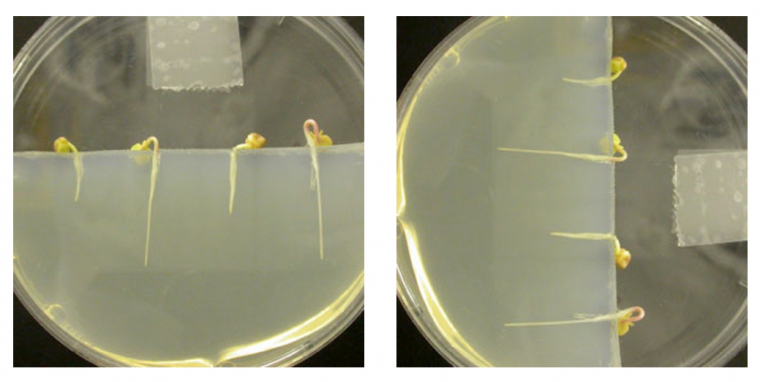

Cet article propose des méthodes pour obtenir, facilement mais de façon rigoureuse, des mises en évidence du gravitropisme chez les végétaux, en travaillant sur des germinations ou de jeunes plantes.
Introduction
Les végétaux sont sensibles à la gravité et leurs réactions à ce facteur sont responsables en grande partie de leur port dressé. Le gravitropisme est donc un exemple permettant d’illustrer comment les conditions de l’environnement influent sur le phénotype d’un organisme (Pour plus de détails, voir le document « Le gravitropisme des végétaux »). À ce titre il est largement abordé lors des enseignements en lycée.
Toutefois, il est souvent difficile de réaliser des observations et mises en évidence expérimentales démonstratives, qui plus est, dans un temps court. En effet, comme la gravité est omniprésente, le protocole habituellement utilisé en physiologie qui consiste à supprimer ou modifier un facteur pour étudier son effet est impossible dans ce cas sur la Terre. Pour mettre en évidence et analyser le gravitropisme il faut donc procéder autrement : par exemple en modifiant, non le sens de la gravité mais la position de la plante par rapport à elle.
Le présent document propose de faire un bilan de ce qui est observable et démontrable avec des moyens relativement simples, tout en gardant la plus grande rigueur scientifique.
Mise en évidence du gravitropisme sur les organes aériens
Pour les organes aériens, protégés par leur cuticule, il suffit de placer une jeune tige en position couchée (maintenue à sa base avec du ruban adhésif) pour observer son redressement après 2 à 5 heures. La plupart des hypocotyles (soja, tournesol, etc.) et des jeunes tiges épicotylées (petit pois…) conviennent bien.
Voici en photo le résultat obtenu avec une plantule de soja.
A gauche : une plantule de soja est placée horizontalement
A droite : la même plantule de soja, photographiée 4 heures plus tard
Le même résultat est présenté par une vidéo :
Vidéo accélérée montrant l'effet du gravitropisme sur une plantule de soja
Si cette expérience est intéressante car simple à mettre en œuvre, c’est chez les racines que l’analyse scientifique a été la plus approfondie (voir le document « Le gravitropisme des végétaux »). Cependant, sur ce matériel, l’expérimentation pose deux problèmes principaux :
- Comment obtenir des racines droites et verticales ? Les racines doivent en effet être parfaitement droites si l’on veut pouvoir observer une courbure.
- Comment placer les racines sans les léser ? Les racines sont sensibles à la dessication puisque dépourvues de cuticule. Il faut donc travailler très vite et replacer la racine, dont la position a été modifiée, dans des conditions de bonne humidité.
La suite du document propose une solution simple pour chacun de ces deux problèmes et présente quelques résultats.
Comment obtenir des racines droites et verticales ?
La croissance des racines dépend des conditions du semis :
- Si les graines sont placées sur du papier filtre, une mince couche de sable, de vermiculite ou de gélose, les racines partent dans tous les sens. Elles sont tordues et ne croissent pas verticalement.
- Si les graines sont placées sur une grande épaisseur de vermiculite ou de sable, il est nécessaire de les déterrer pour connaître leur longueur car si elles atteignent le fond du récipient, elles se courbent. De toutes façons, elles sont plus ou moins ondulées et des particules adhérentes gênent l’expérimentation.
- Si les graines sont placées sur une grande épaisseur de gélose, on peut suivre leur longueur par transparence et elles sont verticales, mais si on les retire, leurs poils absorbants sont abîmés.
Pour résoudre ces problèmes, voici une proposition de protocole réalisé avec des graines de radis :
- Placer les graines sur une feuille de papier essuie-tout imbibé d’eau.
- Rouler le papier.
- Entourer le rouleau dans un sac en plastique.
- Suspendre le sac verticalement.
En haut, à gauche : Les graines sont placées sur une feuille de papier absorbant imbibé d’eau.
En haut, à droite : La feuille est roulée et suspendue verticalement dans un sac en plastique.
En bas, à gauche : Le papier est déroulé. Les graines ont germé et les racines sont majoritairement orientées verticalement.
En bas, à droite : Agrandissement de l'image de gauche.
Quelle que soit la position d’origine de la radicule, toutes les racines ont poussé vers le bas et sont droites et verticales.
Remarque : Comme on ne voit pas les graines dans le papier il est nécessaire de faire un essai préalable pour connaître le temps de germination.
Comment placer les racines sans les léser ?
Le principe de la manipulation est de prélever des racines droites et verticales et de les placer horizontalement dans de bonnes conditions d’humidité. Il faut que le transfert soit rapide afin d’éviter la dessication et ne pas léser les poils absorbants.
Voici le protocole proposé :
- couler 1 cm de gélose à 1 ou 2 % dans des boîtes de Pétri,
- couper la gélose et en enlever la moitié.
Regarder une vidéo de la manipulation :
- Sur la surface de section de la gélose laissée dans la boîte, faire quelques trous verticaux (de la longueur des racines à l’aide d’une pince courbe ou d’un fil de fer recourbé).
- Planter les germinations dans ces orifices.
- Fermer les boites et placez-les sur leur tranche.
A gauche : La section de la gélose placée horizontalement est percée de trous.
A droite : Les germinations sont placées délicatement dans les trous réalisés dans la gélose.
Regarder une vidéo de la manipulation :
Résultats : on peut faire tourner les boîtes de sorte que les racines soient en position verticale ou horizontale.
A gauche : Les racines ont été plantées verticalement.
A droite : La même boîte expérimentale qu'à gauche, mais celle-ci a été posée sur sa tranche et tournée de 90° de manière à soumettre latéralement les racines à la gravité.
Remarque : si on a préparé les boîtes à l’avance et si on a conservé les germinations dans le papier humide, le contact avec l’air ne dure que quelques secondes et les racines ne sont pas lésées.
Résultats
Pour observer avec précision la réaction gravitropique, il est nécessaire de :
- bien fermer les boîtes de Pétri pour éviter la déshydratation de la gélose,
- placer les boîtes sur la tranche et bien les fixer de manière que les racines restent bien horizontales,
- placer les boîtes de préférence à l’obscurité ou en lumière atténuée pour éviter une réaction phototropique supplémentaire.
La réaction gravitropique est relativement lente. La première indication d’une courbure apparaît au bout d’une heure et devient bien observable après 2 heures d’exposition. Si les boîtes sont gardées bien posées sur la tranche, les réactions sont remarquables après 8 heures ou 24 heures.
Les racines présentent une réaction gravitropique positive, alors que les hypocotyles présentent une réaction gravitropique négative.
Deux vidéos vous sont proposées :
On observe ici une verticalisation de la racine, obtenue non par courbure de la racine préexistante mais par changement de direction de croissance de celle-ci.
Deux vidéos vous sont proposées :